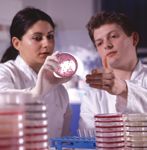
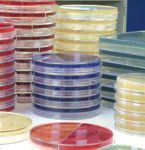

News
Article
Pharmaceutical Technology Europe
Pharmaceutical Technology Europe
Author(s):
The concept of quality should not only apply to the manufacture of the media - it should also continue throughout the product's lifetime of usage.
In the pharmaceutical industry, microbiological culture media play a key role in signalling the presence or absence of microorganisms at any stage of production. For this reason, the validation requirements of the European, United States and Japanese Pharmacopoeias in respect of such media will need no introduction to readers of this publication. Perhaps less well known, however, are the quality criteria that distinguish the many different suppliers of culture media — criteria that can help pharmaceutical contractors provide further reassurance of their own quality systems to their end customer.
The production, quality assurance and post-sales support of culture media make it a demanding and multifaceted business. Because conclusions drawn from the use of these products have a direct impact on quality standards in pharmaceuticals production (and ultimately, on patients' lives) it is hardly surprising that the achievement of excellence in culture media manufacture calls for the highest levels of expertise and control.
In the pharmaceutical industry (just as in clinical diagnostics, food and water testing applications), there is an implicit requirement that microbiological culture media should perform consistently to an agreed specification. This can only be achieved through rigorous application of quality management throughout the manufacturing process. For many years, the quality standard towards which culture media manufacturers in Europe have worked has been BS EN ISO 9001:2000. So, it might have appeared safe to assume that BS EN ISO 9001:2000 registration should be the first key criterion for selecting a culture media supplier.
However, while BS EN ISO 9001:2000 registration signifies compliance with defined quality management standards on a cross-industry basis, there is another more specific standard — ISO 13485:2003 that applies even more closely to culture media manufacture.
This standard is based on the BS EN ISO 9001:2000 quality management standard, but it is oriented specifically towards the design, development, production and installation of medical devices and related services. Closer scrutiny of the requirements of ISO 13485:2003 reveals its relevance to the exacting standards of the pharmaceutical industry. It is a process standard (as opposed to a product standard), which not only encompasses the operation of a quality management system, but also focuses on meeting customer expectations and, crucially, compliance with regulatory requirements.
Whenever BS EN ISO 9001:2000 requires a supplier to document a procedure, it also calls for the implementation and maintenance of that procedure. ISO 13485:2003 goes further by extending the 'document, implement and maintain' requirement to include the meeting of specific customer/industry needs. In addition, it places greater emphasis on using procedures to control and regulate the way in which specific processes and activities should be performed. This gives culture media purchased from ISO 13485:2003 registered suppliers a clear competitive edge.
However, ISO registration is not the only external assessment criterion against which a potential supplier can be evaluated. Culture media suppliers that are audited by FDA can be identified on the agency's website (www.fda.gov).
Your chosen supplier should also be able to demonstrate a proactive stance in keeping up-to-date on changes in legislation and regulatory requirements. Ensure that your audit questions this area — does the manufacturer have staff dedicated to this activity?
Having short-listed a potential supplier on the basis of its ISO and/or FDA registration, the next step is to make your own enquiries into the nature of its quality systems. Normally, the vehicle for such enquiries would be an audit, conducted either in the form of a written questionnaire or a site visit.
Often, written questionnaires follow a standard format based on criteria specific to pharmaceuticals manufacture. It should be borne in mind, however, that key criteria for culture media selection are somewhat different to those that would typically apply to pharmaceuticals. In practice, site visits may yield more meaningful information than questionnaires when selecting a culture media supplier. It is helpful in this context if those involved in the audit from the contractor's side have been able to gain a broad understanding of the processes involved in manufacturing culture media. It is essential that the potential supplier should be able to demonstrate in-depth understanding of the requirements of pharmaceuticals production.
Additional questions about the supplier's quality systems include:
It is vital to assess their knowledge of standards and guidelines that affect the pharmaceuticals industry and indeed their ability to monitor the introduction of relevant, new regulations as and when they arise.
Face-to-face assessments will yield much more information than tick box responses to standard questions. Plus, they provide an invaluable feel for the supplier's organization, in terms of its overall competence and ability to provide ongoing support to its customers.

Key points
This is an important, yet seemingly intangible aspect of culture media selection. Those who make procurement decisions are seldom the same individuals who will have to prepare and work with the media on the laboratory bench. Laboratory technicians may, from time to time, need advice on aspects of media performance or storage. Availability of technical support to product end-users is an essential resource for ensuring that media are prepared, stored and utilized correctly. In this context, the concept of quality should not only apply to the manufacture of the media — it should also continue throughout the product's lifetime of usage.
Other aspects of a supplier's customer service should also be taken into consideration, such as the efficiency of their sales and order processing operations:
Although these issues may at first seem less important than product quality, they are factors that can greatly benefit you as the product user, and help to offer reassurance to your customers.
Product quality and performance will, nevertheless, remain the primary focus of any supplier assessment audit, requiring detailed investigation into the scope and efficacy of the manufacturer's quality systems. While the primary responsibility for quality lies with the manufacturer of microbiological culture media, regulatory requirements dictate that consumers must also perform tests on incoming products for validation purposes. By selecting suppliers that are fully conversant with the requirements of the pharmaceutical industry, it is possible to benefit from potentially time and money saving synergy in regard to their quality and your required validation.
The level of detail in the quality documentation that a manufacturer issues to accompany its products should be a key factor in supplier selection. For example, product specifications should provide all the relevant details, such as typical formulation, test and pass criteria against which product performance is assessed, and with which standards these performance tests comply. Quality control certificates giving batch-specific information and quantitative test results are considered advantageous, and are readily available with each consignment or electronically. Other documents demanded by pharmaceutical companies include certificates of origin, which provide the appropriate reassurance in relation to the source of material of ruminant origins in a given product.
Your audit might also ask if your chosen supplier provides culture media to other industry sectors such as food microbiology and for clinical applications. If so, its products will also be subject to particularly stringent systems of testing that utilize methods and reference organisms relevant to all these different end-use areas — thus enhancing confidence in their performance.
It is the combination of the quality issues addressed here, and the culture media manufacturers' in-depth appreciation of the requirements and working practices of the pharmaceutical industry that will set the very best of the suppliers apart from the rest.
Elaine Nichols is the quality assurance manager at Oxoid Ltd (UK).
Get the essential updates shaping the future of pharma manufacturing and compliance—subscribe today to Pharmaceutical Technology and never miss a breakthrough.